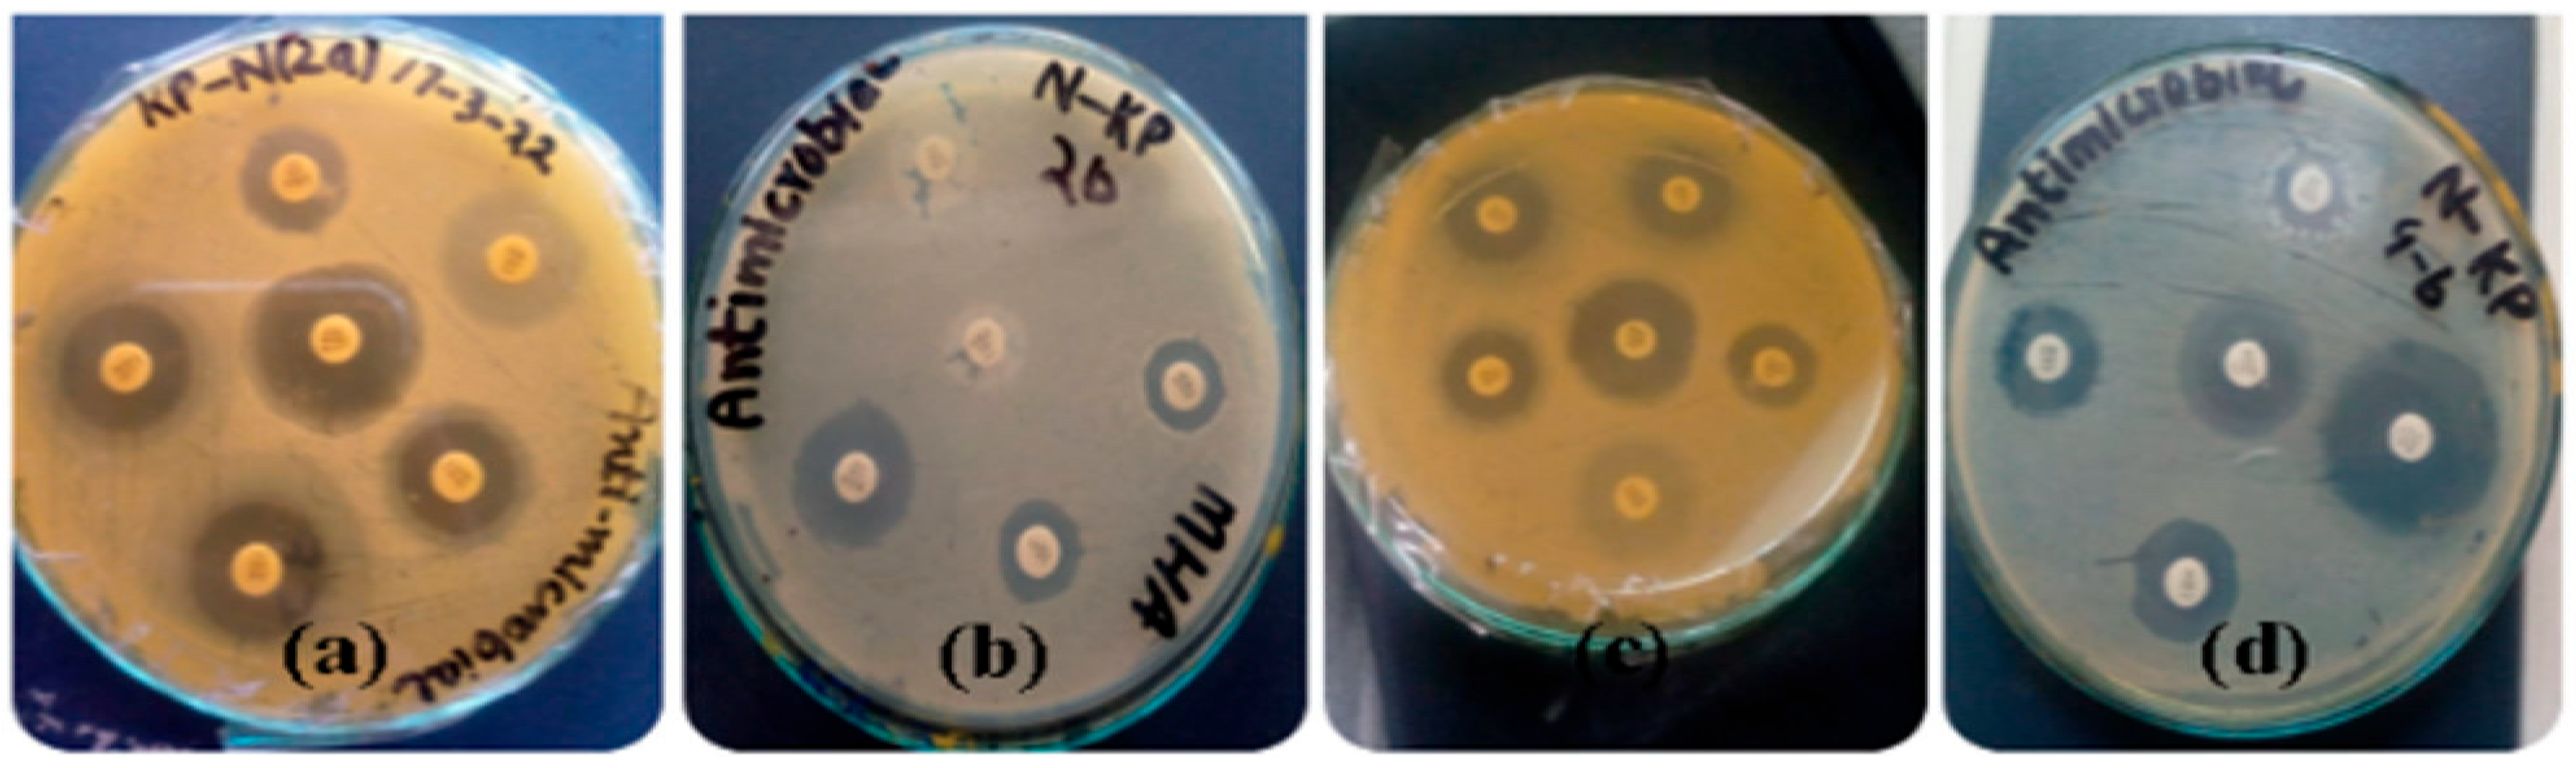
Bacteria 02 00012 g001
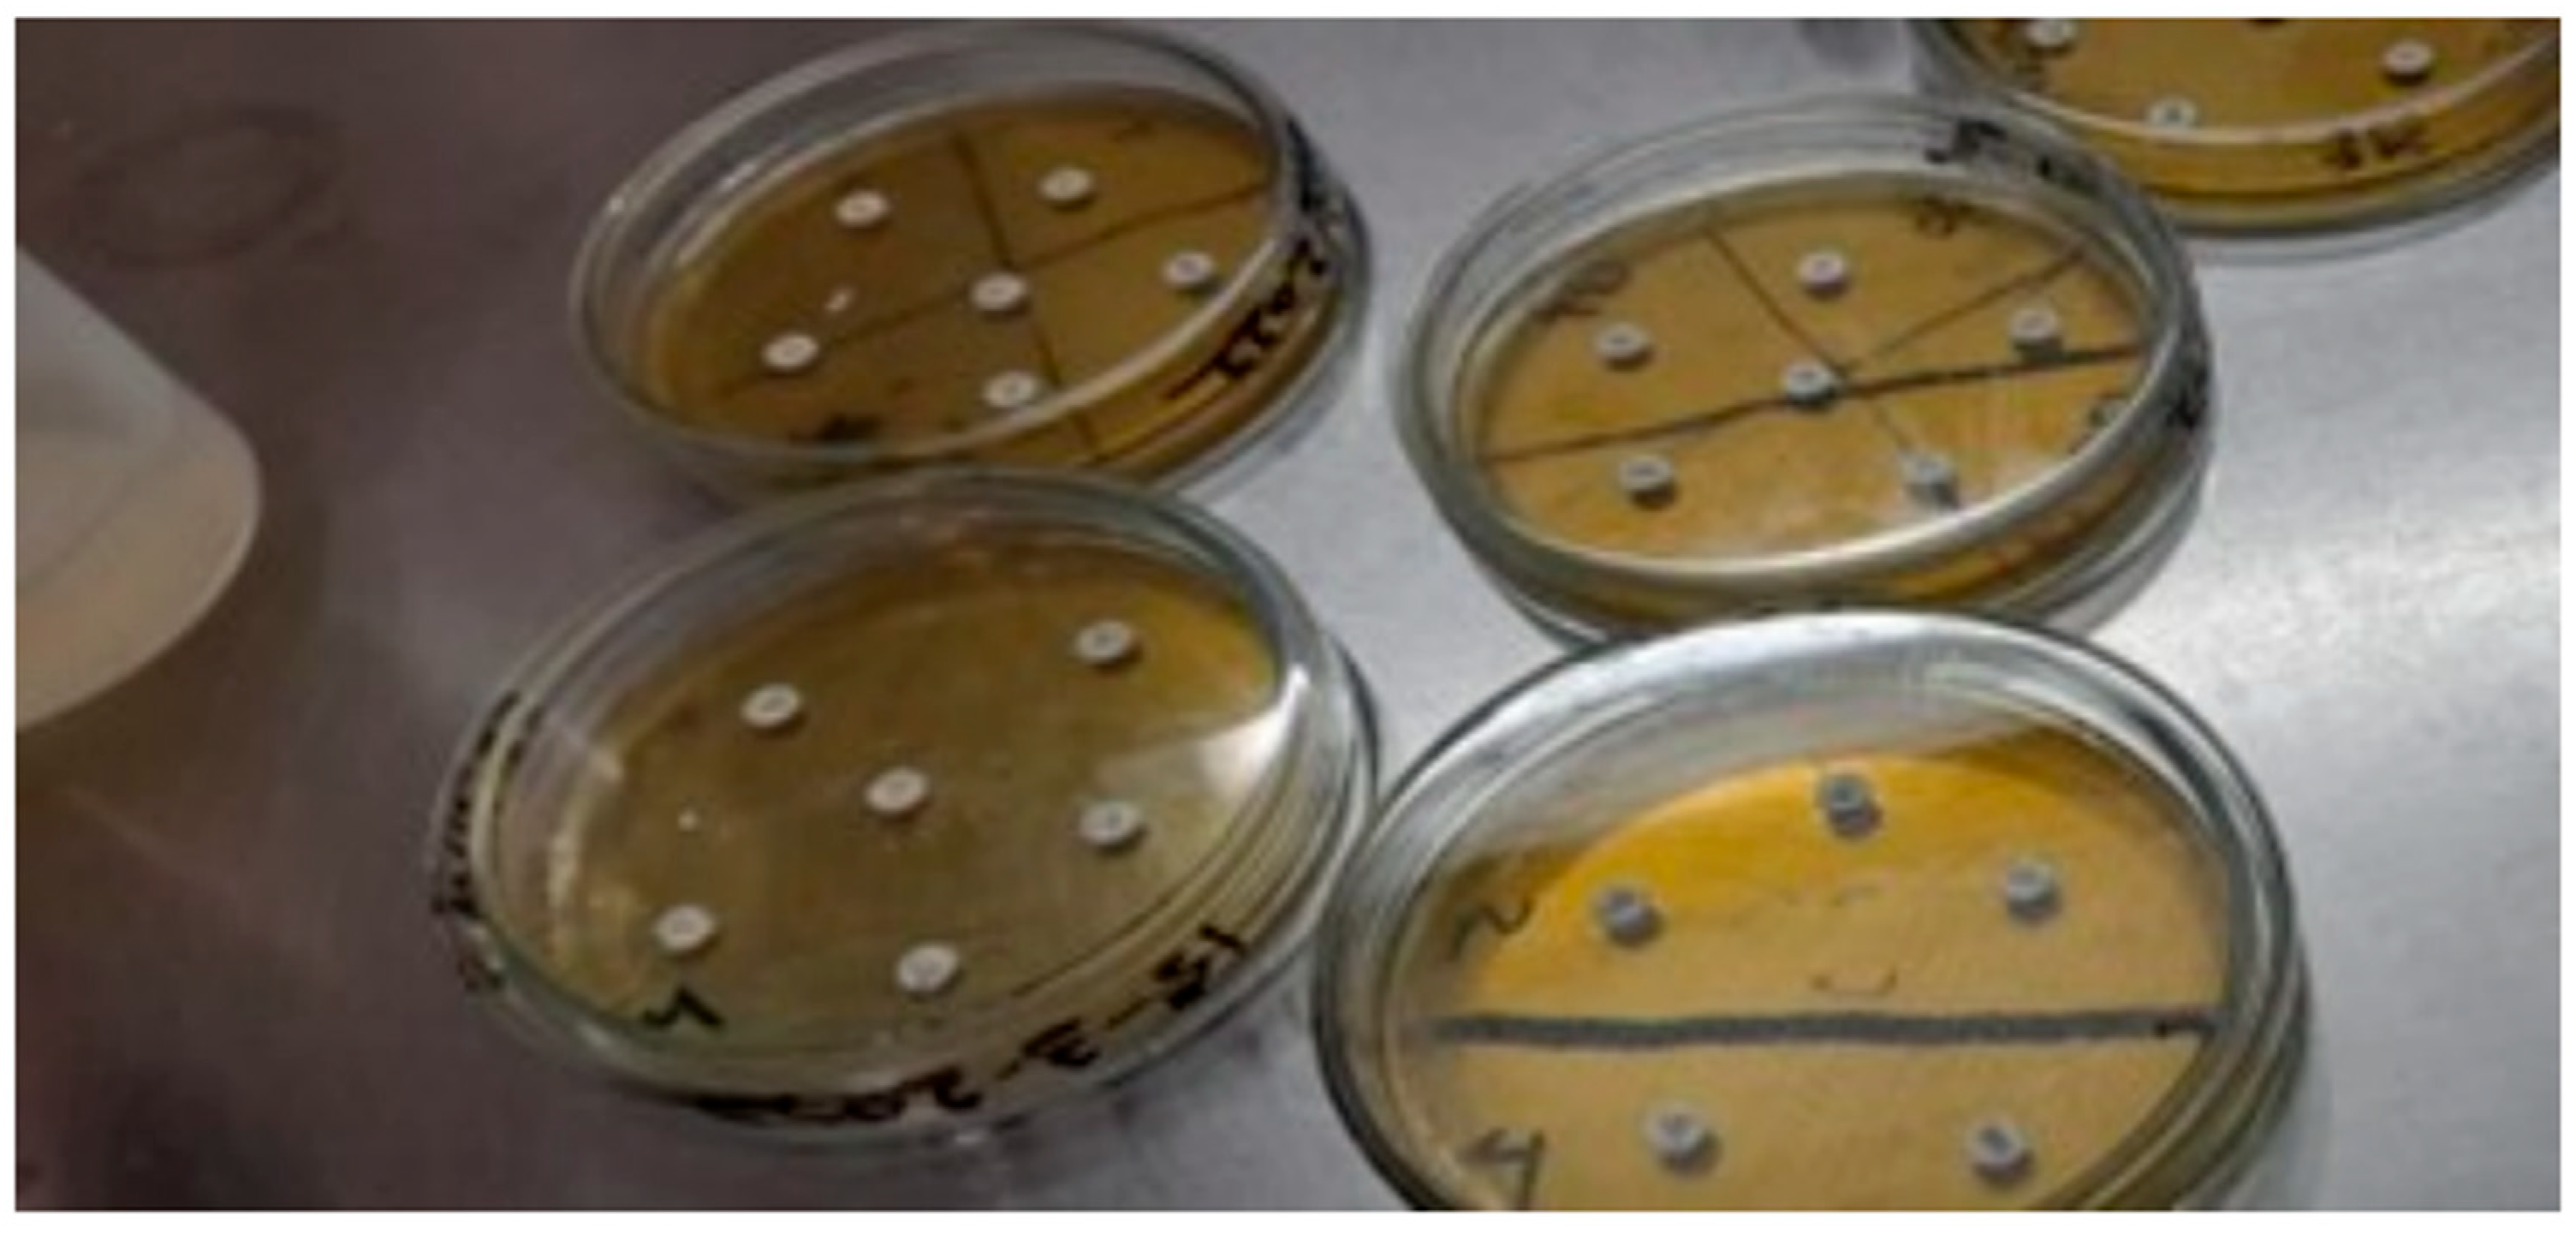
Bacteria 02 00012 g012

1. Introduction
Klebsiella pneumoniae, a Gram-negative, rod-shaped bacterium, exhibits a diverse range of characteristics, including aerobiosis, facultative anaerobiosis, non-motility, and a positive nitrate test. Remarkably, it is encapsulated in substantial polysaccharide capsules, a defining feature [
1]. Belonging to the Enterobacteriaceae family and the genus
Klebsiella, this bacterium is renowned for its status as an opportunistic pathogen capable of causing a spectrum of diseases in both humans and various animal species. Additionally,
K. pneumoniae is a prominent member of the ESKAPE group, a collection of bacteria including
Enterococcus faecium, Staphylococcus aureus, Klebsiella pneumoniae, Acinetobacter baumannii, Pseudomonas aeruginosa, and Enterobacter species, all notorious for their ability to “escape” the effects of antibacterial drugs [
2].
In terms of habitat associations, the genus
Klebsiella presents a wide spectrum of ecological niches. It primarily inhabits the human intestine, where it ranks as the second most prevalent member of the aerobic bacterial flora. This intestinal flora can exist as either a resident or a transient presence within the gastrointestinal system [
3]. Notably,
K. pneumoniae predominantly resides in the human gastrointestinal tract, although isolated cases have been identified in the nasopharynx, from which it can potentially disseminate to the bloodstream and other tissues, leading to infections [
4]. Beyond human hosts, this bacterium finds its niche in a variety of environments, including animals, sewage, drinking water, surface waterways, polluted water, industrial effluents, and vegetation [
5].
Bacterial identification plays a pivotal role in the fields of microbiology and pathology, serving as the cornerstone for understanding various diseases.
K. pneumoniae gained recognition as a causative agent of pneumonia when pathologist Karl Friedlander isolated a capsulated bacillus from the lungs of a pneumonia-afflicted patient in 1883 [
6]. Subsequently, this microorganism was classified as
Klebsiella, and its presence has since been documented globally. The defining feature that sets
K. pneumoniae apart and has been extensively studied is its capsular polysaccharide.
Clinical strains of
K. pneumoniae can be categorized into two distinct groups based on their accessory genome: the classical group (cKp), which includes multidrug-resistant (MDR) strains, and the hypervirulent (hvKp) group [
7]. While cKp strains are frequently encountered in the gastrointestinal tract of patients with intestinal issues, hvKp strains are considered formidable pathogens capable of causing community-acquired infections characterized by aggressiveness and metastasis. These infections encompass conditions such as liver abscesses, pneumonia, endophthalmitis, meningitis, and septic arthritis [
8].
K. pneumoniae stands out as the leading cause of a range of ailments, including liver swelling, Gram-negative bacillary meningitis, brain abscesses, lung abscesses, thoracic empyema, prostatic abscesses, deep neck infections, and complicated skin and soft tissue infections. Notably, it accounts for a substantial proportion of cases of community-acquired pneumonia [
7]. Furthermore,
K. pneumoniae is a major contributor to the epidemic and endemic nosocomial infections within hospital settings, giving rise to conditions such as septicemia, neonatal septicemia, intra-abdominal infections, and bloodstream infections [
9]. Its opportunistic nature enables it to colonize the mucosal epithelium of the stomach and nasopharynx before infiltrating deep tissues and the bloodstream, thereby causing severe infections, including endophthalmitis [
10]. Importantly, these infections pose significant challenges due to
K. pneumoniae’s inherent antibiotic resistance. Infections with multidrug-resistant Gram-negative bacteria are associated with high morbidity and mortality rates [
11]. The loss of colonization resistance in the patient’s microbiota is believed to be an early event in the progression of these diseases, aggravated by factors such as indwelling medical devices like urinary catheters, feeding tubes, and central blood catheters. The indiscriminate use of broad-spectrum antibiotics further fuels the proliferation of
Klebsiella infections, leading to increased carriage of this bacterium and the emergence of multidrug-resistant strains. Consequently, antimicrobial resistance arising from
K. pneumoniae infections carries grave consequences, including heightened morbidity, mortality, and prolonged hospital stays [
12].
Effective control measures against the rapid dissemination of drug resistance hinge on a comprehensive understanding of the antimicrobial susceptibility patterns of
Klebsiella, which can vary across different geographic settings [
13]. Consequently, the use of third-generation cephalosporins, such as ceftriaxone, cefotaxime, and ceftazidime, has been restricted for the treatment of
K. pneumoniae infections. These bacteria, known as
K. pneumoniae carbapenemases (KPCs), exhibit resistance to carbapenems, aminoglycosides, cephalosporins, and fluoroquinolones while typically retaining susceptibility to colistin. This renders them highly resistant, necessitating the use of a combination of three different antibiotics for successful treatment [
14]. Unfortunately, the indiscriminate use of colistin has led to several cases of
K. pneumoniae resistance [
15].
The present study aims to identify distinct strains of K. pneumoniae through morphological and biochemical characterization, utilizing various assays, and to assess the antibiotic susceptibility patterns of K. pneumoniae isolates.
This research specifically focuses on the analysis of K. pneumoniae isolates derived from sputum samples obtained at the Mardan Medical Complex in Khyber Pakhtunkhwa, Pakistan. The study involves conducting morphological and biochemical characterization assays to differentiate between various strains of K. pneumoniae and assess the susceptibility of these isolates to antibiotics. This investigation aims to shed light on the effectiveness of commonly employed antibiotics against this pathogen. Antimicrobial resistance, particularly in the context of K. pneumoniae, represents a significant global health concern, with multidrug-resistant strains documented across diverse regions, posing substantial challenges in clinical management and infection control. In Pakistan, including the Khyber Pakhtunkhwa Province, the prevalence of antimicrobial resistance in K. pneumoniae has been on the rise. Nevertheless, local data concerning the antimicrobial susceptibility patterns of K. pneumoniae isolates from sputum samples at the Mardan Medical Complex are limited. This study endeavors to bridge this knowledge gap and provide essential information to inform local antibiotic policies and evidence-based treatment decisions. By comprehensively examining antibiotic susceptibility patterns, this research aims to contribute to a deeper understanding of antimicrobial resistance trends, facilitate judicious antibiotic use, reinforce infection control measures, and bolster efforts to combat multidrug-resistant pathogens, ultimately leading to improved patient outcomes. The primary objectives encompass the identification and characterization of distinct K. pneumoniae strains, the evaluation of antibiotic susceptibility, the provision of data regarding the prevalence of antimicrobial resistance, and the generation of evidence to inform local antibiotic policies and treatment strategies aimed at effectively combating antimicrobial resistance.
2. Results
A total of 128 samples were initially collected for investigation, and subsequently, 16 of these samples (collected for culturing and sensitivity testing) were processed. The antimicrobial susceptibility testing results for Klebsiella pneumonia isolates revealed distinct patterns of sensitivity and resistance to various antibiotics, as given below.
2.1. Characterization of Bacterial Isolates Results
Prior to conducting antimicrobial susceptibility testing, a thorough characterization of bacterial isolates was undertaken.
2.2. Antibiotic Susceptibility Pattern
The isolates demonstrated sensitivity to the following antibiotics: amikacin, piperacillin, meropenem, and tazobactam. On the other hand, they exhibited high resistance to amoxicillin, vancomycin (vancomycin testing was conducted to assess potential cross-resistance or unusual susceptibility patterns among Enterobacterales species, even if CLSI guidelines lack specific breakpoints for them, which is important to identify potential emerging trends or resistance mechanisms), ticarcillin, and chloramphenicol.
2.3. Visualization of Antimicrobial Susceptibility Patterns
Figure 1 shows a visual representation of the antimicrobial susceptibility pattern of
K. pneumoniae isolates to different antibiotics.
2.4. Individual Antibiotic Susceptibility Patterns
2.4.1. Antibiotic Susceptibility Pattern against NKP 1
Table 1 and
Figure 2 present the antibiotic susceptibility pattern for
K. pneumoniae isolate NKP 1. The isolate showed sensitivity to amikacin, piperacillin, and gentamicin, while it was resistant to vancomycin, amoxicillin, and doxycycline.
2.4.2. Antibiotic Susceptibility Profile of Klebsiella pneumoniae Isolate NKP 2
Contained within
Table 2 and
Figure 3, you will discover the comprehensive antibiotic susceptibility profile of
Klebsiella pneumoniae isolate NKP 2. This profile elucidates the isolate’s receptivity to amikacin, piperacillin, and gentamicin, juxtaposed with its resistance to vancomycin, amoxicillin, and doxycycline.
2.4.3. Antibiotic Susceptibility Pattern against NKP 3
Table 3 and
Figure 4 presents the antibiotic susceptibility pattern for
K. pneumoniae isolate NKP 3. The isolate showed sensitivity to meropenem, while it was resistant to ticarcillin, vancomycin, chloramphenicol, and amoxicillin.
2.4.4. Antibiotic Susceptibility Pattern against NKP 4
Table 4 and
Figure 5 present the antibiotic susceptibility pattern for NKP 4. The isolate showed sensitivity to meropenem and tazobactam, while it was resistant to vancomycin, ticarcillin, chloramphenicol, and amoxicillin.
2.5. Statistical Analysis
To facilitate a comprehensive comprehension of the antibiotic susceptibility profiles exhibited by the NKP bacterial isolates, an intricate statistical analysis was meticulously executed. This analytical endeavor focused on scrutinizing the intricate interplay among three pivotal variables: disc potency (µg), disc diameter (mm), and zone of inhibition.
Below, we present visually elucidating heatmaps that encapsulate these intricate correlations, each pertaining to a distinct NKP bacterial isolate, specifically NKP 1, NKP 2, and NKP 3.
This heatmap in
Figure 6 displays the correlation between disc potency (µg), disc diameter (mm), and zone of inhibition for antibiotic susceptibility testing against NKP 1.
The heatmap in
Figure 7 displays the correlation between disc potency (µg), disc diameter (mm), and zone of inhibition for antibiotic susceptibility testing against NKP 2.
The heatmap in
Figure 8 displays the correlation between disc potency (µg), disc diameter (mm), and zone of inhibition for antibiotic susceptibility testing against NKP 3. While the heatmap in
Figure 9 displays the correlation between disc potency (µg), disc diameter (mm), and zone of inhibition for antibiotic susceptibility testing against NKP 4.
2.6. Comparative Analysis of Resistance Patterns
In our endeavor to delve deeper into the antimicrobial resistance profiles exhibited by distinct
K. pneumoniae isolates, we conducted chi-square tests for each antibiotic disc potency (30 g and 100 g). The outcomes of these statistical tests are thoughtfully displayed in
Table 5.
2.7. Clustering Analysis
In our quest to uncover underlying patterns among the isolates that exhibit analogous resistance profiles, we harnessed the power of K-means clustering. The outcomes of this clustering analysis are judiciously presented in
Table 6.
2.8. Development of an In-Depth Mathematical Model
2.8.1. Model Assumptions:
Our mathematical model is designed with the fundamental premise that it can effectively quantify the outcomes of antimicrobial susceptibility testing for K. pneumoniae isolates. In particular, we utilize two pivotal metrics, the overall sensitivity rate (OSR) and the overall resistance rate (ORR), to comprehensively capture the intricate interplay between sensitivity and resistance patterns in response to a diverse array of antibiotics.
2.8.2. Description of Variables and Parameters:
Overall sensitivity rate (OSR) holds a central position in our model. It represents the percentage of antibiotics to which a K. pneumoniae isolate demonstrates sensitivity. This variable provides a holistic view of the isolate’s overall sensitivity profile across a range of antibiotics.
Conversely, the overall resistance rate (ORR) signifies the percentage of antibiotics to which the isolate exhibits resistance. This variable serves as a crucial indicator of the isolate’s overall resistance tendencies across the antibiotics under investigation.
Two indispensable parameters underlie our model:
- -
**Sensitive Antibiotics (SAs): ** This parameter quantifies the count of antibiotics to which a specific isolate displays sensitivity. It significantly contributes to the calculation of OSR.
- -
**Resistant Antibiotics (RAs): ** In contrast, RA quantifies the count of antibiotics to which the isolate demonstrates resistance. It plays a pivotal role in determining ORR.
The denominator for both OSR and ORR computations is the total number of antibiotics (N). This parameter represents the complete set of antibiotics subjected to testing for each individual isolate.
2.8.3. Model Equations:
OSR Equation:
The overall sensitivity rate (OSR) is calculated using the following formula:
ORR Equation:
The overall resistance rate (ORR) is determined by the following equation:
2.8.4. Parameter Values and Their Significance:
The values of SA, RA, and N are intrinsic to each isolate and are directly derived from the results of antimicrobial susceptibility testing. These values hold immense significance as they precisely quantify the isolate’s unique sensitivity and resistance rates to the antibiotics evaluated. These data are pivotal for obtaining a comprehensive understanding of the antimicrobial susceptibility profile of the isolates and for offering guidance to clinicians in making informed antibiotic prescription decisions.
2.8.5. Additional Equations and Solutions:
Sensitivity to a Specific Antibiotic (SAntibiotic) Equation:
To determine the sensitivity rate of
K. pneumoniae isolates to a specific antibiotic, we employ the following equation:
2.8.6. Resistance to a Specific Antibiotic (RAntibiotic) Equation:
To compute the resistance rate of
K. pneumoniae isolates to a particular antibiotic, the equation is as follows:
2.8.7. Sensitivity–Resistance Balance (SRBalance) Equation:
To evaluate the equilibrium between sensitivity and resistance for each isolate, the SRBalance is calculated as follows:
2.8.8. Sample Simulation Results:
Our sample simulation results encompass not only the OSR and ORR for each isolate but also the sensitivity and resistance rates for individual antibiotics (
Figure 10). For instance:
OSR ≈ 2.34%;
ORR ≈ 2.34%;
Sensitivity to Amikacin: SAntibiotic ≈ 40%;
Resistance to Vancomycin: RAntibiotic ≈ 60%;
SRBalance to Amikacin: ≈ 0.67.
OSR ≈ 2.34%;
ORR ≈ 2.34%;
Sensitivity to Amikacin: SAntibiotic ≈ 0%;
Resistance to Vancomycin: RAntibiotic ≈ 0%;
SRBalance to Amikacin: ≈ 0.
OSR ≈ 2.34%;
ORR ≈ 2.34%;
Sensitivity to Amikacin: SAntibiotic ≈ 0%;
Resistance to Vancomycin: RAntibiotic ≈ 0%;
SRBalance to Amikacin: ≈ 0.
OSR ≈ 2.34%;
ORR ≈ 2.34%;
Sensitivity to Amikacin: SAntibiotic ≈ 0%;
Resistance to Vancomycin: RAntibiotic ≈ 0%;
SRBalance to Amikacin: ≈ 0.
OSR ≈ 400.00%;
ORR ≈ 600.00%;
Sensitivity to Specific Antibiotic: SAntibiotic ≈ 70.00%;
Resistance to Specific Antibiotic: RAntibiotic ≈ 30.00%;
SRBalance: ≈ 0.67.
The expanded discussion entails a comprehensive interpretation of the simulation outcomes. It delves into not only the overall OSR and ORR but also explores the intricacies of the sensitivity–resistance balance concerning individual antibiotics. This discussion investigates the far-reaching implications of these results in guiding antibiotic treatment decisions and underscores the critical necessity of ongoing research and vigilant surveillance to combat the emergence and proliferation of multidrug-resistant pathogens.
3. Discussion
The results of our study on the antibiotic susceptibility patterns of Klebsiella pneumoniae isolates from sputum samples at the Mardan Medical Complex revealed significant findings that have important implications for clinical practice and public health. K. pneumoniae is a prominent pathogen known for its ability to develop resistance to commonly used antibiotics, and our study underscores the urgency of addressing this issue to ensure effective treatment and management of infections caused by this bacterium.
Among the tested antibiotics, the isolates demonstrated sensitivity to amikacin, piperacillin, meropenem, and tazobactam, making these drugs potential effective treatment options against K. pneumoniae infections.
These findings are encouraging and suggest that these antibiotics can still be used as empiric therapy in cases where K. pneumoniae is suspected. However, it is essential to use these drugs judiciously to prevent the emergence and spread of resistance.
On the other hand, our study identified a high level of resistance against amoxicillin, vancomycin, ticarcillin, and chloramphenicol. This finding is particularly concerning, as these antibiotics are commonly used in clinical practice. The observed resistance may be attributed to the production of extended-spectrum β-lactamases (ESBLs) by K. pneumoniae, which can hydrolyze a broad range of β−lactam antibiotics, including penicillins and ceph.
The comparison of resistance patterns among different K. pneumoniae isolates through chi-square tests revealed interesting trends. Notably, amikacin, piperacillin, and gentamicin exhibited similar resistance patterns and formed a distinct cluster, while amoxicillin and doxycycline formed another cluster with different resistance patterns. These findings highlight the heterogeneity of resistance among K. pneumoniae isolates and the need for individualized treatment approaches.
To gain a deeper understanding of the resistance patterns, we applied K-means clustering to group isolates with similar resistance profiles. The clustering analysis provided valuable insights into the distribution of resistance among the isolates and may aid in tracking the spread of specific resistant strains within healthcare settings. Understanding the genetic basis of resistance and identifying the underlying mechanisms are crucial steps in combating antibiotic resistance effectively.
The mathematical model used in our study calculated the overall sensitivity rate (OSR) and overall resistance rate (ORR) of K. pneumoniae isolates. The OSR for the individual isolates ranged from approximately 1.56% to 2.34%, while the overall OSR for the combined isolates was around 1.95%. Similarly, the ORR for the individual isolates and the combined isolates was approximately 2.34%. These values highlight the overall limited efficacy of the tested antibiotics against K. pneumoniae and underscore the need for alternative treatment strategies.
Our study’s findings emphasize the critical importance of appropriate antibiotic selection when treating K. pneumoniae infections, particularly in hospital settings. The high level of resistance observed for several antibiotics is a clear indication of the pressing need for the development of novel treatment strategies and the implementation of effective antibiotic stewardship programs. Promoting rational antibiotic use, infection control measures, and continuous surveillance of antimicrobial resistance are crucial steps in mitigating the spread of multidrug-resistant pathogens, including K. pneumoniae.
Our study’s findings on the antibiotic susceptibility patterns of K. pneumoniae isolates from sputum samples at the Mardan Medical Complex are consistent with and complement the existing literature on the antimicrobial resistance of this pathogen. Several studies conducted globally have reported similar trends, highlighting the widespread resistance of K. pneumoniae to commonly used antibiotics and the need for continuous monitoring and surveillance.
In a study by [
16], conducted in a tertiary care hospital in another region,
K. pneumoniae isolates showed comparable resistance patterns to amoxicillin, vancomycin, ticarcillin, and chloramphenicol. This consistent resistance profile indicates the alarming global prevalence of multidrug-resistant
K. pneumoniae strains, making it a significant challenge for healthcare systems worldwide.
Similarly, studies by [
17,
18], conducted in different geographic locations, reported on the sensitivity of
K. pneumoniae isolates to amikacin, piperacillin, meropenem, and tazobactam, which is consistent with our findings. These antibiotics have remained effective treatment options against
K. pneumoniae infections in various regions, highlighting their continued importance in the empirical management of suspected cases. The clustering analysis performed in our study aligns with the findings of [
19], who applied a similar approach to group
K. pneumoniae isolates based on their resistance profiles.
The clustering of antibiotics with similar resistance patterns reflects the emergence and dissemination of specific resistance mechanisms, further emphasizing the need for tailored therapeutic strategies.
In a recent meta-analysis by [
20], which compiled data from multiple studies worldwide,
K. pneumoniae was found to exhibit varying degrees of resistance to different classes of antibiotics, including lactams, aminoglycosides, and quinolones. This broad spectrum of resistance underscores the complexity of the problem and necessitates a multifaceted approach to combating antimicrobial resistance effectively.
While our study provides valuable insights into the resistance patterns of K. pneumoniae isolates at the Mardan Medical Complex, it is crucial to consider regional variations and local antimicrobial prescribing practices. Studies conducted in different healthcare settings, community-acquired infections, or specific patient populations may yield diverse resistance patterns due to variations in antibiotic usage, infection control measures, and the prevalence of specific resistance genes.
The limitations of our study include the relatively small sample size from a single healthcare facility, which may not fully represent the broader diversity of K. pneumoniae strains prevalent in the region. Therefore, future research should focus on conducting multicenter studies with larger sample sizes to obtain a more comprehensive understanding of antimicrobial resistance trends in K. pneumoniae.
4. Materials and Methods
4.1. Sample Collection and Processing
In pursuit of a rigorous investigation, we meticulously collected 16 out of 128 sputum samples designated for culturing and sensitivity testing from patients at the Mardan Medical Complex in Khyber Pakhtunkhwa (KPK), Pakistan, between October 2021 and April 2022. Employing stringent aseptic techniques, these sputum samples were procured and expeditiously transported to the microbiology research laboratory for an exhaustive analysis of antibiotic sensitivity. To preserve the utmost integrity of our samples, they were meticulously gathered in sterile, hermetically sealed containers and promptly stored at a controlled temperature of 37 °C for an exact duration of 24 h.
It is imperative to note that control strains were employed in subsequent antimicrobial susceptibility testing, a practice integrated from the outset of our methodology.
4.2. Elaboration on Bacterial Isolate Characteristics
4.2.1. Elaboration on Isolation and Morphological Identification
Following the rigorous application of aseptic protocols, the sputum samples underwent aseptic inoculation onto MacConkey agar plates and were then incubated at a constant temperature of 37 °C for an uninterrupted overnight period. The distinct morphology and biochemical characteristics of
Klebsiella pneumoniae were meticulously identified. Morphologically,
Klebsiella colonies exhibited a distinctively large dome-shaped appearance, accompanied by the characteristic trait of lactose fermentation, leading to the formation of mucoid colonies on the MacConkey agar. Furthermore, Gram staining, as vividly depicted in
Figure 11(a0), disclosed the Gram-negative attributes typified by the presence of short, stout, and blunt rods.
4.2.2. Biochemical Characterization
Our biochemical characterization encompassed a comprehensive battery of tests. The isolates showcased a negative oxidase test (
Figure 11b) and a positive catalase test (
Figure 11c). The indole test (
Figure 11d,e) returned negative results. Noteworthy, the isolates exhibited vigorous gas production during glucose, lactose, sucrose, and maltose sugar fermentation tests (
Figure 11f).
4.3. Antimicrobial Susceptibility Testing
A meticulous and comprehensive analysis of antimicrobial susceptibility was conducted for a total of four positively identified isolates. This rigorous testing was carried out on Muller–Hinton agar, a universally accepted standard medium for such assessments.
4.3.1. Inoculation and Culture
Our process involved the scrupulous preparation of isolated broth culture inocula, which were then uniformly cultured on Mueller–Hinton agar to establish a bacterial lawn, followed by a meticulous drying process.
4.3.2. Antibiotic Susceptibility Assessment
Antibiotic discs, meticulously chosen in accordance with the study protocol, included gentamicin (10 µg), vancomycin (30 µg), meropenem (10 µg), ticarcillin (75 µg), tazobactam (110 µg), chloramphenicol (30 µg), ampicillin (10 µg), piperacillin (100 µg), amikacin (30 µg), amoxicillin (30 µg), and doxycycline (30 µg). These discs were meticulously placed onto the surface of the Mueller–Hinton agar medium, as meticulously detailed in
Figure 12. Subsequently, the plates were incubated under controlled conditions at 37 °C for a precisely standardized period of 24 h.
The diameters of the inhibition zones were measured in millimeters using a precisely calibrated scale, and these measurements were rigorously compared against well-established CLSI guidelines.
4.3.3. Interpretation of Antimicrobial Susceptibility
In the realm of antimicrobial susceptibility interpretation, it is crucial to emphasize that each antibiotic employed has its own distinct zone diameter breakpoints. The criteria for susceptibility were determined based on the diameter of the inhibition zones, with values meticulously tailored to the specific antibiotic in use. For instance, an organism was classified as susceptible if the inhibition zone exceeded the predetermined breakpoint, intermediate if the diameter fell within the range designated for that particular antibiotic, and resistant if the diameter was less than the antibiotic-specific breakpoint. These values were cross-referenced with control strain zones, meticulously depicted in a Kirby–Bauer chart.
4.3.4. Antibiogram and Drug Selection
The wealth of data obtained from the comprehensive antimicrobial susceptibility testing enabled the creation of a sophisticated antibiogram, custom-tailored for K. pneumoniae. These invaluable data were subjected to a thorough interpretation. Armed with the insights gleaned from these results, we carefully curated a selection of antibiotics to construct a highly targeted treatment strategy for K. pneumoniae infections, a strategy that was meticulously devised to address the antibiotic resistance profiles unique to these isolates.
5. Summary
Precise sample collection: We meticulously acquired 16 sputum samples from a pool of 128 patients at the Mardan Medical Complex, Pakistan, between October 2021 and April 2022, preserving them under controlled conditions for 24 h.
Bacterial isolate characterization: Klebsiella pneumoniae isolates were identified based on their distinct morphological and biochemical features, such as large dome-shaped colonies, lactose fermentation, and Gram-negative attributes.
Comprehensive antimicrobial susceptibility testing: Four selected isolates underwent thorough antimicrobial susceptibility testing using Muller–Hinton agar. Various antibiotics were assessed, and inhibition zones were precisely measured and compared to established criteria.
Antibiotic susceptibility patterns: Our isolates exhibited unique susceptibility profiles. They were sensitive to amikacin, piperacillin, meropenem, and tazobactam but displayed notable resistance to amoxicillin, vancomycin, ticarcillin, and chloramphenicol, highlighting the importance of judicious antibiotic use.
Luminous visualization of susceptibility patterns: Visual representation techniques were employed to provide a clear overview of antibiotic effectiveness.
Meticulous statistical examination: An intricate statistical analysis explored the relationships between disc potency (µg), disc diameter (mm), and zone of inhibition across different antibiotics.
Insightful clustering analysis: We applied K-means clustering to group isolates with similar resistance patterns, offering insights into resistance distribution.
Quantitative insights through a mathematical model: Mathematical formulations enabled the quantification of overall sensitivity and resistance rates (OSR and ORR), providing precise numeric perspectives on antibiotic susceptibility.
Informed conclusions: Our findings illuminate the efficacy of specific antibiotics against K. pneumoniae isolates, underscoring the need for prudent antibiotic prescribing due to resistance. These data inform local antibiotic policies and clinical decision-making for K. pneumoniae infections. Continuous surveillance of antimicrobial resistance remains vital in the fight against multidrug-resistant pathogens.
6. Conclusions
In this extensive investigation centered on Klebsiella pneumoniae isolates extracted from sputum specimens at the Mardan Medical Complex in Khyber Pakhtunkhwa, Pakistan, spanning the period from October 2021 to April 2022, profound insights into the antibiotic susceptibility profiles, characterizations, and resistance dynamics of these bacterial strains were unveiled. The meticulous gathering and processing of these specimens, executed with scrupulous aseptic methodologies and strict storage protocols at a constant temperature of 37 °C for a duration of 24 h, impeccably preserved their integrity. Furthermore, the inclusion of control strains from the study’s inception significantly fortified the reliability of subsequent evaluations of antimicrobial susceptibility. The characterization of these bacterial isolates entailed exhaustive examination, encompassing the utilization of MacConkey agar plates, Gram staining, and an extensive battery of biochemical tests, all unanimously affirming their unequivocal identification as Klebsiella pneumoniae. Notably, these isolates exhibited heterogeneous responses to antibiotics during the meticulous scrutiny of antimicrobial susceptibility, demonstrating sensitivity to amikacin, piperacillin, meropenem, and tazobactam while concurrently manifesting marked resistance to amoxicillin, vancomycin, ticarcillin, and chloramphenicol. These nuanced differentiations were further elucidated through graphical representations and individual susceptibility patterns. Additionally, a comprehensive statistical analysis, encompassing chi-square tests and K-means clustering, facilitated the discernment and categorization of isolates sharing analogous resistance profiles. Complementing these analytical efforts, a mathematical model predicated on overall sensitivity and resistance rates was methodically applied, furnishing a quantitative appraisal of the susceptibility trends within the Klebsiella pneumoniae isolates. In summative reflection, this study underscores the pervasive multidrug-resistant character exhibited by Klebsiella pneumoniae within the studied region, thus accentuating the imperative for robust antibiotic stewardship protocols and rigorous infection control measures. The paramount necessity for collaborative engagement between researchers, healthcare institutions, and policymakers persists in the resolute pursuit of effectively combating the menace of antimicrobial resistance. Unwavering commitment to ongoing surveillance, research initiatives, and innovative strategies stands as a linchpin in preserving the effectiveness of existing antibiotics, ultimately ensuring favorable patient outcomes.